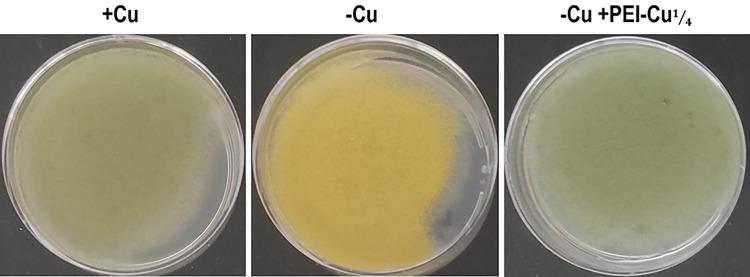
https://cdn.ncbi.nlm.nih.gov/pmc/blobs/f920/12154136/7ef395dcaf8d/nihpp-rs5895555v1-f0004.jpg

对机会性真菌病原体构巢曲霉的静止分生孢子和芽管具有抗真菌活性的铜螯合超支化聚乙烯亚胺
Copper-Chelated Hyperbranched Polyethyleneimines with Antifungal Activity against quiescent conidia and germlings of the opportunistic fungal pathogen Aspergillus nidulans.
作者信息
Tsiourvas Dimitris, Sideratou Zili, Mavrogonatou Eleni, Kletsas Dimitris, Sophianopoulou Vicky, Gerostathis Spiros
机构信息
Institute of Nanoscience and Nanotechnology, National Centre for Scientific Research "Demokritos".
Laboratory of Cell Proliferation and Ageing, Institute of Biosciences and Applications (IBA), National Centre for Scientific Research "Demokritos".
出版信息
Res Sq. 2025 May 30:rs.3.rs-5895555. doi: 10.21203/rs.3.rs-5895555/v1.
The rising number of immunocompromised individuals, combined with the severity of fungal infections in the general population, has contributed to a significant increase in opportunistic fungal infections, which are often associated with high mortality rates. Existing antifungal drugs, although effective, operate via a narrow range of mechanisms, leading to the rapid development of resistance, while they also primarily target growing host cells. Therefore, the need to develop next-generation antifungal agents that function via a broad range of mechanisms and/or to target dormant/quiescent cells is of great importance. In the present study, we investigate the characteristics and the potential antifungal properties of a series of copper-chelated hyperbranched polyethyleneimines (PEI-Cu) of various Cu:primary amino groups of PEI (Cu:N) molar ratios, using the opportunistic pathogen Aspergillus nidulans as a model microorganism. Our results showed that, despite their dissociation, the PEI-Cu¼ and PEI-Cu〿16 complexes with Cu:N molar ratios of 1:4 and 1:16, respectively, exhibit an apparent fungicidal activity on A. nidulans quiescent conidiospores, while in A. nidulans germlings they affect the hyphal growth rate, produce ROS and alter their mitochondrial morphology network. In addition, no cytotoxic effects were observed on normal human skin fibroblasts at concentrations and incubation times that were entirely inhibitory for A. nidulans. Overall, our results suggest that the investigated PEI-Cu complexes are promising antifungals and their underlying mechanism of action deserves further investigation, especially against drug-resistant quiescent fungal cells.
免疫功能低下个体数量的增加,再加上普通人群中真菌感染的严重性,导致机会性真菌感染显著增加,而这些感染往往与高死亡率相关。现有的抗真菌药物虽然有效,但作用机制较为单一,导致耐药性迅速发展,同时它们主要靶向生长中的宿主细胞。因此,开发通过多种机制发挥作用和/或靶向休眠/静止细胞的下一代抗真菌药物至关重要。在本研究中,我们以机会性病原体构巢曲霉为模型微生物,研究了一系列不同铜与聚乙烯亚胺(PEI)伯氨基摩尔比(Cu:N)的铜螯合超支化聚乙烯亚胺(PEI-Cu)的特性和潜在抗真菌特性。我们的结果表明,尽管会解离,但Cu:N摩尔比分别为1:4和1:16的PEI-Cu¼和PEI-Cu〿16复合物对构巢曲霉静止分生孢子表现出明显的杀菌活性,而在构巢曲霉芽管中,它们会影响菌丝生长速率,产生活性氧并改变其线粒体形态网络。此外,在对构巢曲霉具有完全抑制作用的浓度和孵育时间下,未观察到对正常人皮肤成纤维细胞的细胞毒性作用。总体而言,我们的结果表明,所研究的PEI-Cu复合物是有前景的抗真菌剂,其潜在作用机制值得进一步研究,尤其是针对耐药性静止真菌细胞。